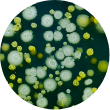

Aukščiausios klasės šilkas.
Šimtmečius vertinama medžiaga turinti švelnią tekstūrą, blizgų paviršių ir sukelianti prabangos jausmą.
Back
Basket reserved: 0 val. 15 min. 00 sec.
Prisidėkite 1 užvalkalą ir gaukite: 30% nuolaida šilkinei miego kaukei
Save by buying more

Noreo 3D Natural silk sleep mask
€24,99
€49,98
Color
Šimtmečius vertinama medžiaga turinti švelnią tekstūrą, blizgų paviršių ir sukelianti prabangos jausmą.


Šilkas - prabangos prekė, ne tik, dėl jo brangaus pagaminimo, bet ir dėl išskirtinės naudos jums.













ryte jų oda buvo gaivesnė ir švaresnė

jo plaukai buvo mažiau suvelti ir susipynę

jų miego kokybė pagerėjo po 4 naktų

ryte jų oda buvo gaivesnė ir švaresnė

jo plaukai buvo mažiau suvelti ir susipynę

jų miego kokybė pagerėjo po 4 naktų
Medžiagos tiesiai iš gamtos yra tai ką turime geriausio. Todėl mes naudojame 100% natūralų, aukščiausios kokybės mulberry šilką. Mes keliame savo produktų kokybės standartą kiekvieną dieną, jokių pridėtinių toksinų su OEKO-TEX sertifikatu.



![]() Gali sukelti odos paraudimus
Gali sukelti odos paraudimus
![]() Puiki vieta veistis bakterijoms
Puiki vieta veistis bakterijoms
![]() Dažnas plovimas ir vėdinimas
Dažnas plovimas ir vėdinimas

![]() Temperatūros reguliavimas
Temperatūros reguliavimas
![]() Negamina bakterijų
Negamina bakterijų
![]() Reikalauja 3 kartus mažiau plovimo
Reikalauja 3 kartus mažiau plovimo
![]() Švelnūs plaukai
Švelnūs plaukai


Noreo komanda tiki jog medžiagos kilusios iš gamtos turi daugiausiai naudingų savybių. Mes atidžiau stebime šilko patalynės gamybos procesą tam, kad suteiktume jums aukščiausios kokybės komfortą.
Noreo komanda tiki jog medžiagos kilusios iš gamtos turi daugiausiai naudingų savybių. Mes atidžiau stebime šilko patalynės gamybos procesą tam, kad suteiktume jums aukščiausios kokybės komfortą.

![]() Gali sukelti odos paraudimus
Gali sukelti odos paraudimus
![]() Puiki vieta veistis bakterijoms
Puiki vieta veistis bakterijoms
![]() Dažnas plovimas ir vėdinimas
Dažnas plovimas ir vėdinimas




![]() Temperatūros reguliavimas
Temperatūros reguliavimas
![]() Negamina bakterijų
Negamina bakterijų
![]() Reikalauja 3 kartus mažiau plovimo
Reikalauja 3 kartus mažiau plovimo
![]() Švelnūs plaukai
Švelnūs plaukai
Kokoną sudaro vientisas iki 3000 m ilgio siūlas.

Išvirti kokonai dedami į vėsesnį vandenį ir vyniojami ant specialios ritės.

Iš suverpto šilko pradedamas gaminti itin aukštos kokybės audinys.

Dažomi natūraliai: medžių šaknimis, kario milteliais, bananmedžių lapais ar kt.

Paruošta medžiaga perduodama gamybai, kurioje gimsta Noreo užvalkalai.
